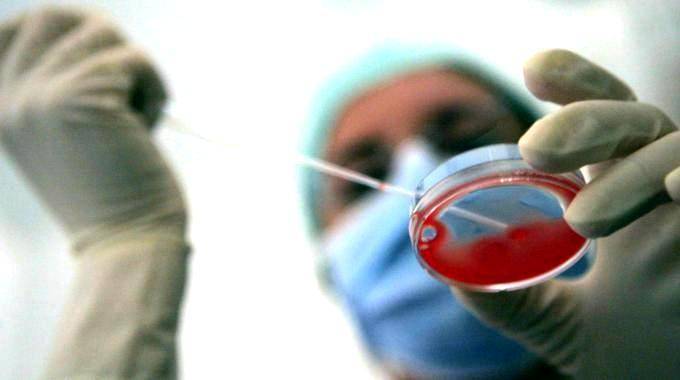

Fecondazione assistita, no al seme congelato del marito morto
- Postato il 27 dicembre 2025
- Attualità
- Di Il Giornale
- 2 Visualizzazioni
Fecondazione assistita, no al seme congelato del marito morto